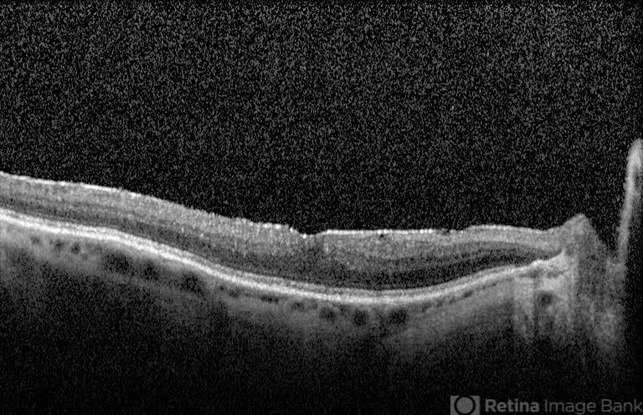

-
 By Peter G. Hovland, MD, PhD
By Peter G. Hovland, MD, PhD
Colorado Retina Associates
Co-author(s): Alan Kimura MD - Uploaded on Jul 17, 2018.
- Last modified by Caroline Bozell on Jul 19, 2018.
- Rating
- Appears in
- Melanoma Associated Retinopathy
- Condition/keywords
- retinopathy
- Photographer
- Colorado Retina Associates
- Imaging device
- Fundus camera
- Description
- OCT of 70-year-old male with metastatic cutaneous melanoma, 2 years after diagnosis of melanoma associated retinopathy, (MAR)

Initializing download.
Initializing download.
---thumb.jpg/image-square;max$79,0.ImageHandler)







